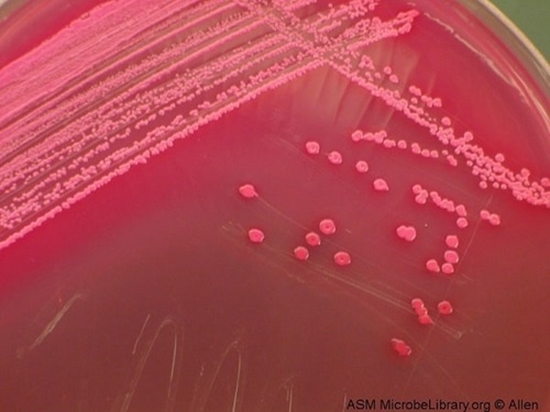

بررسی نشانه های بالینی شواهد پاراکلنیکی بیماران مبتلا به عفونت با سویه های پر خطر انتروباکتر کلوآکه و تعیین سکانس تایپ سویه ها
مرکز هدف اول: م ت. مقاومت میکروبی و مدیریت مصرف آنتی بیوتیک ها
این مطالعه به بررسی نشانههای بالینی و شواهد پاراکلنیکی بیماران مبتلا به عفونتهای ناشی از سویههای پرخطر Enterobacter cloacae پرداخته و به تعیین سکانس تایپ سویهها میپردازد. هدف اصلی تحقیق، شناسایی ویژگیهای بالینی و آزمایشگاهی بیماران مبتلا به این نوع عفونتها و همچنین تحلیل تنوع ژنتیکی سویههای مختلف است. سویههای Enterobacter cloacae به دلیل قابلیت مقاومت به آنتیبیوتیکها و توانایی ایجاد عفونتهای شدید، به ویژه در بیماران با نقص ایمنی، اهمیت بالایی دارند. نتایج این مطالعه میتواند به بهبود تشخیص زودهنگام و مدیریت درمان این عفونتها کمک کرده و همچنین اطلاعات مهمی در مورد انواع سویههای این باکتری و مکانیسمهای مقاومت آن فراهم آورد.
مجری طرح: دکتر مریم نخستین



ارسال نظر